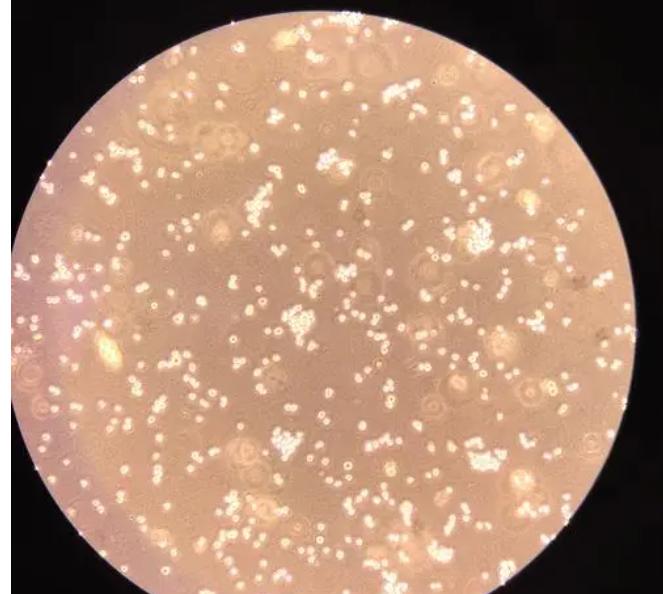
蓝藻球菌的完整细胞MALDI-TOF质谱分析，用于分类和鉴定标记蛋白

前言:
蓝藻的原核细胞结构简单,具有光合作用能力的细菌叶状体特征,会产生蓝藻毒素从而导致中毒或健康问题。

我们在这项研究中使用基质溶剂,从蓝藻完整细胞中提取蛋白质,经过聚丙烯酰胺凝胶电泳进行分离, 将分离得到的蛋白质在凝胶中进行消化 ,并利用液相色谱来分析所得到的肽。
生物材料和显微镜
在无菌液体Z培养基中,将分析的菌株孵育三周,使用100ml锥形瓶或直径为9cm的1.5%琼脂平板(温度:22°C;光照/黑暗循环:16/8小时;光照强度:20μmol·m-2·s-1)。

收获细胞的方法为液体培养时以260g离心10分钟,或从琼脂平板上简单刮除,最后,使用光学显微镜进行检查。
细菌检测标准品、肽校准标准品II以及α-氰基-4-羟基肉桂酸(CHCA)、有机溶剂、甲酸和三氟乙酸均属于分析纯度等级。

使用刮刀,将收获的蓝藻细胞等分为试样,并将其放入1.5ml管中,轻轻地用去离子水涡旋洗涤细胞一段时间。
在洗涤步骤中,通过以5,000×g的短时间离心, 将细胞收集在相同体积的去离子水中, 以开发一种简单快速的程序。

完整细胞的制备
蓝藻细胞的MALDI-TOFMS分析是在配备氮气激光器的Microflex LRF20仪器上进行的,使用波长为337 nm的激光器,脉冲重复率为60 Hz。
在反射正离子模式下,设置加速电压为1.19 kV(IS0),提取电压为2.15 kV,透镜电压为9.0 kV,反射器电压为20.0 kV,检测器电压为1668 V,脉冲离子提取延迟时间为500 ns,以获取质谱数据。

完整细胞马尔迪质谱法 (IC MALDI-MS)
质谱的检查范围从m/z 1000到m/z 20,000,使用细菌测试标准进行外部校准,覆盖平均质量在3637.8和16952.3 Da之间。
采用二元基质系统制备MALDI二元基质体系-1 ,其中包括阿魏酸(5 mg·ml)和芥子酸(15毫克·毫升),以2:7的体积比溶解在*腈乙**和3%(v/v)TFA的混合物中。

将细胞悬液以1μl的量施加到目标板上(MSP BigAnchor 96 BC microScout Target;布鲁克Daltonik),与相同体积的基质溶液混合并干燥,形成结晶的样品/基质共晶体。
在方案开发过程中,将沉积在靶标上的细胞悬浮样品用1μl25%(v/v)FoA覆盖,风干,然后再次用1μl基质溶液覆盖。

处理来自 IC MALDI-MS 的数据
使用两种软件工具对获得的数据集进行处理:MALDI Biotyper 3.1和Biospean,在MALDI Biotyper中,从实验数据创建并保存参考光谱(即主光谱投影,MSP)到数据库中。
通过包括至少70%的采集光谱中表示的峰,并且以峰值最大值的m/z值公差为±2质量单位的方式,生成虚拟参考光谱,将这些参考光谱相互比较以评估它们之间的相似性。

在Biospean中,通过将检测到的相同峰位置数除以检测光谱中总共检测到的峰数,得出一个评分值,用于表示相似性的程度。
蛋白质提取
将生长的蓝藻培养物从500ml锥形瓶转移到250ml聚丙烯离心比色皿中,以13,000×g的速度旋转30分钟。
使用玻璃棒帮助将每个比色皿中的颗粒悬浮在5mL的MALDI基质溶剂中,即ACN/2%(v/v)TFA,以7:3的体积比混合。

将悬浮液(每个物种组合在一起)转移到15ml管中,在23°C和750RPM的热混合器中摇动14小时。
通过以10,000×g的速度离心20分钟,并将蛋白质提取物作为上清液收集,在-20°C冷冻储存。
在冷冻时,样品分为两个相,底部相为无色或微弱的绿色冰,上相为液体且有色,在进一步的分析之前,通过移液除去上层液相并将其废弃。

解冻时,底部水相(5-6ml)在55°C的旋转真空蒸发器上浓缩至约2ml的体积,然后在45°C的真空离心机中完全干燥, 将固体材料溶解在含有6%β-巯基乙醇的Laemmli样品缓冲液中(400μl),进行短时间超声处理并在5°C下加热19分钟。
通过加入100μl的5M NaOH制备碱性最终溶液,如不立即用于电泳,则在-50°C下冷冻储存。
电泳
使用Mini-Protean II设备和PowerPac通用电源(Bio-Rad,Hercules,CA,USA),在1毫米厚的平板聚丙烯酰胺迷你凝胶中进行蛋白质电泳。

分离凝胶使用的是10%T,2.7%C的凝胶,而堆积凝胶则是4%T,2.7%C的凝胶。
将从蛋白质提取物样品中取得的样品(见上文)以25μL等分试样的形式上样,与蛋白质标准品一起在130V的恒定电压下进行分离,直到溴酚蓝示踪染料到达凝胶板底部。
电极缓冲液(pH 8.8)包含0.025M Tris-HCl、0.192M甘氨酸和0.1%(w/v)十二烷基硫酸钠,在分离完成后,将凝胶中的蛋白质在10%(w/v)TCA中固定10分钟。

在1%(w/v)TCA中进行至少2小时的洗涤步骤,然后用去离子水短暂洗涤5次,最后使用生物安全的考马斯染色剂溶液(Bio-Rad)对凝胶进行染色。
凝胶内消化
在通过质谱法鉴定蛋白质之前, 按照标准方案进行凝胶内消化 ,在加入胰蛋白酶之前,需要进行脱色、还原和烷基化步骤。
采用棉子糖修饰的热稳定胰蛋白酶,使用5%(v/v)FoA/ACN的提取溶剂(比例为1:2,v/v)从消化物中提取肽,在真空离心机中进行干燥,并将其储存于-20°C。
蛋白质鉴定
在Microflex LRF 20 MALDI-TOF质谱仪上进行蓝藻细胞的IC MALDI-MS,该仪器是一种标准的台式设备,适用于微生物的常规鉴定,测量是在反射器正离子模式下进行的,以提高质量分辨率。

通过尽可能准确地测量质量数,可以更准确地与从鉴定蛋白质的氨基酸序列中推断出的质量进行比较,选择了二元FA:
SA基质来制备MALDI样品点,在靶标上形成,这种基质化合物组合已被证明对于测量真菌完整细胞或孢子的MALDI谱图是一个不错的选择。
需要优化样品制备程序,将最初用于真菌的方法转移到蓝藻中,这些优化包括:1-调整基质和三氟乙酸(TFA)的浓度;2-评估样品沉积技术。

PCR扩增和测序
我们测试了FA:SA混合物,浓度为10:30 mg·ml-1和5:15 mg·ml-1,以及在*腈乙**中以0.1–5%(体积比)TFA的7:3体积比溶解。
结果显示,在质谱中,使用后者能够获得更好的峰的数量和强度。
我们比较了在基质溶液中使用0.1%、2%或5% TFA时的MALDI-TOF质谱差异 ,并尝试了干燥的液滴样品沉积技术(将细胞悬浮液与基质直接混合并施加到靶板上)。

使用2% TFA时可以得到最佳的肽/蛋白质谱,我们还尝试了其他两种样品沉积技术:混合体积法和两层技术。
无论如何,干燥液滴技术被证明是最佳的,建立了一个完整的蓝藻细胞MALDI质谱库,其中包含所研究蓝藻的肽/蛋白质谱, 对于具有相似或远距离光谱分布的物种,我们在示例中展示了初步比较结果。

讨论:
进一步使用优化的基质溶剂,从蓝藻细胞中提取蛋白质,采用模拟样品沉积的靶向提取条件,提取物在-20°C下冷冻储存,并分为底部相为冰块,顶部相为液态,含有浓缩的绿色(或紫色)色素。
我们对古巴柯氏球菌(CCALA 043)、紫罗兰格洛杆菌(PCC 7421)和集球藻属(UPOC S4)进行了蛋白质鉴定。

为了制备用于1-D凝胶电泳的蛋白质样品,我们只使用底部提取相,因为它的蛋白质含量比顶部有机相高得多,同时也可以去除色素。
在溶剂蒸发后,残留固体的量大约在15-30mg之间(来自200ml细胞培养物),并且通过Laemmli样品缓冲液进行额外提取。
随后,我们通过SDS-PAGE分离了蓝藻蛋白质,CCALA 043的分离蛋白质可见于图4。在可视化后,通过修饰的胰蛋白酶进行凝胶内消化, 酶解产生的肽进行脱盐处理 ,并通过与ESI-MS/MS或MALDI-MS/MS相结合的nanoLC进行分析,。
蛋白质鉴定结果总结在S1表中,在鉴定的蛋白质中,通常包括光合作用相关蛋白质(来自光系统I和II的蛋白质、细胞色素、)核糖体蛋白、核酸相关蛋白、氧化还原和转运蛋白、酶、调节蛋白,以及许多功能尚未表征的蛋白质。
结果:
我们使用nanoLC-ESI-MS/MS技术,在CCALA 158中鉴定了20种分子量低于043 kDa的蛋白质,PCC 7421中鉴定了7421种蛋白质,以及UPOC S4中鉴定了4种蛋白质,使用nanoLC-MALDI-MS/MS技术,相应的数量分别为54、40和67个蛋白质。

将36种蛋白质(基于分子量的一致性)与CCALA 043的IC MALDI-MS谱图中的特征肽峰相匹配(其中34个来自ESI结果,17个来自MALDI结果,使用两种电离技术发现了15个)。
在PCC 7421的情况下,我们找到了21种蛋白质匹配(其中18种来自ESI结果,7种来自MALDI结果;使用ESI和MALDI发现了4种)。
对于UPOC S4,找到了24种蛋白质与IC MALDI质谱相匹配:16种来自ESI结果,9种来自MALDI结果,并且仅通过ESI和MALDI实验发现了一种蛋白质。

结论:
我们的实验中揭示了蓝藻存在几个主要系统发育谱系,这是通过使用分子标记物(如16S rRNA)来实现的,除了16S rRNA外,其他标记物(如ITS区域、nifH或cpcA-cpcB基因)也已成功应用于蓝藻的分类。
这一方法在蓝藻分类中展示了高潜力,具有灵敏度高、操作时间短和成本低的特点,我们使用MALDI-TOF核糖体蛋白分析技术鉴定了铜绿假单胞菌的两个无毒分支和三个有毒分支。
在每个分支内,我们发现菌株之间的距离相当长,这表明在菌株水平上,MALDI-TOF MS方法具有很高的变异性和敏感性。

参考例文:
埃雷罗A,弗洛雷斯E,《 基因组学和进化 》
盖特勒 L. 蓝藻科《瑞士与瑞士植物》
斯坦尼尔 RY, 西斯特罗姆 WR《国际细菌命名法》
4. Anagnostidis K, Komárek J. 《蓝藻分类系统的现代方法》
5. 科马雷克 J,《蓝原核生物(蓝藻属)的分类学分类 》